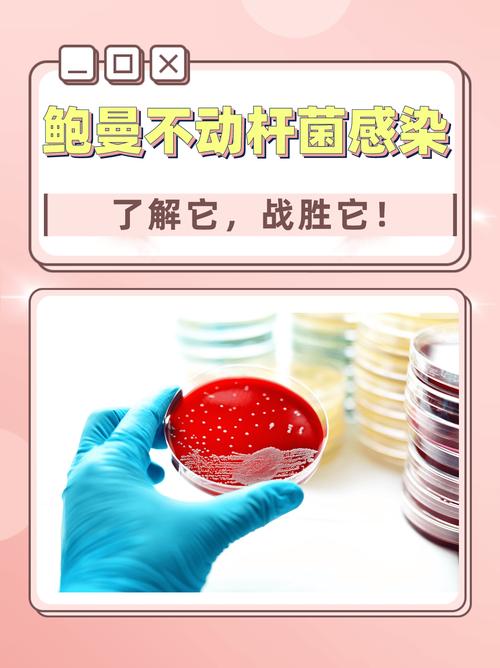
新生儿感染鲍曼不动杆菌的高危因素与防控策略有哪些？-第2张图片-郑州医学网

这是一个非常严肃的医疗问题,因为它关系到最脆弱的群体——新生儿,我会从以下几个方面为您进行详细解释:

- 鲍曼不动杆菌是什么?
- 为什么新生儿是高危人群?
- 新生儿感染鲍曼不动杆菌的来源和途径是什么?
- 感染后有哪些症状?
- 如何诊断和治疗?
- 如何预防和控制?
鲍曼不动杆菌是什么?
- 身份:鲍曼不动杆菌(Acinetobacter baumannii)是一种广泛存在于自然界(如土壤、水)和医院环境中的革兰氏阴性杆菌。
- 特点:
- “超级细菌”:它最令人畏惧的特点是极强的耐药性,特别是多重耐药和泛耐药菌株,对临床上常用的多种抗生素(如青霉素类、头孢菌素类、碳青霉烯类等)天然或获得性耐药,治疗选择非常有限,因此被称为“超级细菌”。
- 生命力顽强:它能在干燥的物体表面(如床栏、监护仪、门把手)长期存活,这使其在医院环境中极易传播。
- “机会主义者”:它通常不会感染健康人,但对于免疫力低下的人群,如重症患者、早产儿、术后患者等,则是一个致命的威胁。
为什么新生儿是高危人群?
新生儿,尤其是早产儿、低体重儿和患有其他疾病的新生儿,是鲍曼不动杆菌感染的最高危人群,原因如下:
- 免疫系统不成熟:新生儿的免疫系统尚未发育完全,抵抗力非常弱,无法有效抵抗细菌的入侵。
- 皮肤黏膜屏障脆弱:新生儿皮肤娇嫩,容易有破损;许多医疗操作(如插管、吸痰)会破坏皮肤和黏膜的天然屏障,为细菌入侵打开了“方便之门”。
- 基础疾病多:许多新生儿(尤其是NICU中的患儿)患有呼吸窘迫综合征、窒息、先天性心脏病等基础疾病,身体状态差,更容易发生感染。
- 侵入性医疗操作频繁:新生儿重症监护室中的患儿常常需要接受各种侵入性操作,如:
- 气管插管和机械通气:细菌可能通过插管管壁进入下呼吸道。
- 中心静脉置管:细菌可能通过置管部位进入血液,引发血流感染。
- 脐静脉/动脉导管:这是早产儿常见的生命支持通道,也是感染的高风险点。
- 导尿:可能引发尿路感染。
- 长期住院:住院时间越长,接触医院环境和耐药菌的机会就越多。
感染的来源和途径
- 主要来源:医院环境是鲍曼不动杆菌最主要的来源,它可以在NICU的设备、仪器、台面、医护人员的手上长期存在。
- 传播途径:
- 接触传播:最主要的传播方式,被污染的医护人员的手是导致交叉感染的关键,被污染的医疗设备(如呼吸机、监护仪、听诊器)和环境表面也是重要的传播媒介。
- 母婴传播:虽然不常见,但如果母亲携带或感染了鲍曼不动杆菌,可能在分娩过程中或产后将细菌传给新生儿。
- 自身菌群移位:新生儿自身肠道、皮肤等部位的菌群失调,也可能导致原本不致病的鲍曼不动杆菌过度增殖并引发感染。
感染后的常见症状
鲍曼不动杆菌可以引起新生儿多种严重的感染,症状取决于感染部位:
- 败血症/血流感染:这是最严重、最致命的类型,表现为:
- 全身反应:体温不稳定(发热或体温不升)、反应差、精神萎靡、喂养困难、呼吸急促或暂停。
- 循环衰竭:面色苍白、四肢发凉、皮肤出现花纹、心率快、血压下降。
- 黄疸:可能突然加重或出现。
- 肺炎:最常见的感染类型之一,表现为:
- 呼吸急促、呻吟、鼻翼扇动、三凹征(吸气时胸骨上窝、锁骨上窝、肋间隙凹陷)。
- 咳嗽(新生儿咳嗽反射弱,可能不明显)。
- 痰液增多,可能为脓性。
- 胸片可见肺部炎性病变。
- 脑膜炎:非常凶险,死亡率高,后遗症严重,表现为:
- 神经系统症状:烦躁不安、嗜睡、抽搐、囟门张力增高或饱满。
- 其他:发热、呕吐(喷射性)。
- 尿路感染:症状可能不典型,可表现为发热、喂养差、体重增长缓慢、尿液浑浊或有异味。
- 皮肤软组织感染:如脐炎、脓疱疮等,表现为局部红肿、化脓。
诊断和治疗
-
诊断:
- 临床诊断:医生会根据新生儿的临床表现、高危因素和实验室检查结果进行综合判断。
- 病原学检查:这是确诊的关键,需要从疑似感染部位无菌采集标本,如血液、脑脊液、痰液、尿液等,进行细菌培养和药敏试验。
- 培养阳性:可以确诊感染。
- 药敏试验:至关重要,它直接指导临床医生选择有效的抗生素,因为鲍曼不动杆菌的耐药性非常复杂。
-
治疗:
(图片来源网络,侵删)
(图片来源网络,侵删)- 治疗原则:早期、足量、联合用药,由于鲍曼不动杆菌多重耐药甚至泛耐药的情况普遍,单一抗生素往往无效。
- 抗生素选择:
- 首选药物:通常需要使用碳青霉烯类抗生素(如亚胺培南、美罗培南)作为经验性治疗,但很多菌株对此已耐药。
- 联合用药:当碳青霉烯类无效时,常需联合使用其他抗生素,如多粘菌素类(如多粘菌素B)、替加环素、氨基糖苷类(如阿米卡星)等,这些药物本身也有一定的肾毒性、耳毒性等副作用,使用时需要严密监测。
- 根据药敏调整:一旦药敏试验结果出来,必须立即调整治疗方案,使用最敏感的抗生素。
- 支持治疗:对于重症患儿,积极的支持治疗是挽救生命的关键,包括呼吸支持(机械通气)、循环支持(使用血管活性药物)、营养支持(静脉营养)等。
预防和控制(重中之重)
由于鲍曼不动杆菌治疗极其困难,预防其传播和控制感染是唯一有效的方法,尤其是在NICU。
- 手卫生:最最重要! 所有接触新生儿的人员(医护人员、父母、探视者)都必须严格遵守七步洗手法,使用含酒精的速干手消毒剂或流动水和肥皂,这是切断传播途径最有效的方法。
- 环境消毒:
- NICU必须进行严格的环境清洁和消毒,尤其是高频接触的物体表面(如床栏、监护仪、治疗车、门把手)。
- 定期对空气、物体表面进行采样监测,及时发现污染源。
- 隔离措施:
- 一旦发现或怀疑患儿感染鲍曼不动杆菌,应立即将其单间隔离,或将同类感染的患儿集中安置。
- 进入隔离病房的医护人员和家属必须穿戴隔离衣、手套、口罩,甚至护目镜。
- 专用的听诊器、血压计、体温计等医疗物品,不得用于其他患儿。
- 合理使用抗生素:避免在NICU中滥用和过度使用广谱抗生素,特别是碳青霉烯类,以减少筛选出耐药菌株的机会。
- 减少侵入性操作:在病情允许的情况下,尽早拔除不必要的导管(如中心静脉导管、气管插管)。
- 严格探视制度:限制不必要的探视,探视者必须穿戴指定的隔离用品,并严格遵守手卫生。
- 对医务人员和家属的教育:提高所有相关人员对鲍曼不动杆菌危害性的认识,并掌握正确的防控措施。
鲍曼不动杆菌对新生儿,特别是NICU中的重症患儿,构成了巨大的威胁,它具有高耐药性、高致病性的特点,一旦引发感染,病情往往非常危重,治疗难度极大,病死率和后遗症发生率都很高。
防控远比治疗更重要,建立一个由医护人员、父母和医院管理层共同参与的、严格的感染控制体系,尤其是狠抓手卫生和环境消毒,是保护这些脆弱生命免受鲍曼不动杆菌侵害的根本之道,如果家长怀疑自己的孩子有感染迹象,应立即寻求专业儿科医生的帮助。

标签: 新生儿鲍曼不动杆菌感染高危因素 新生儿鲍曼不动杆菌防控策略 早产儿鲍曼不动杆菌感染预防






